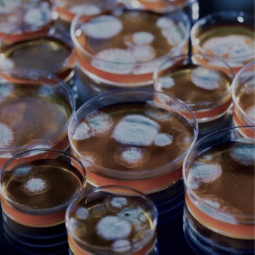

في عالم آخر الفشل يعني أن تعود خائباً لأنك لم تحقق هدفك المنشود، إلا أن هذا ليس صحيحاً في عالم الأبحاث.
في هذا الثريد نستعرض معكم إخفاقات بحثية أدت إلى اكتشافات علمية شكلت ملامح وقتنا الحالي ومنها:
1-النايتروجلسرين
2-البنسلين
3-المينوكسديل
4-الصبغات الصناعية
إعداد: @NAlqurayn
في هذا الثريد نستعرض معكم إخفاقات بحثية أدت إلى اكتشافات علمية شكلت ملامح وقتنا الحالي ومنها:
1-النايتروجلسرين
2-البنسلين
3-المينوكسديل
4-الصبغات الصناعية
إعداد: @NAlqurayn
قاموا بتجربة المنتج على الفئران وأثبت فعاليته، إلا أن استخدامه على البشر لم يكن ممكنا لعدم نقائه. قام Edward Abraham الذي أُستعين به للمشاركة في عملية الاستخلاص بتجربة تقنية جديدة: alumina column chromatography وأثبتت فعاليتها.
لم تكن ظروف الحرب في بريطانيا تسمح لتصنيع البنسلين بكميات كبيرة فسافر العلماء إلى الولايات المتحدة الأمريكية ليستطيعوا تطوير العملية وتصنيعه بكميات أكبر.
لم تظهر الدراسات على البشر نفس التأثير لذلك قام العلماء باستخدام أحد نواتج استقلاب DAM وهو DAMN-O وقاموا بدراسته، كانت النتائج مشجعة إلا أنه تسبب باحتباس الأملاح والسوائل، وظهرت سميته على الكلاب المتمثلة بوجود نزيف في الأذين الأيمن، لذلك تم إيقاف الدراسة.
لم يستسلم الباحثون وقاموا بصناعة عدة نظائر من DAMN-O ومنها Minoxidil الذي أظهر نتائج قوية في تخفيض ضغط الدم إلا أنه كان لا بد من استخدام مدرات البول و beta blockers معه لعلاج احتباس السوائل.
جاري تحميل الاقتراحات...